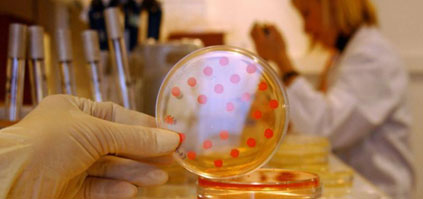
Des microbes résistants aux antibiotiques trouvés chez une population indigène isolée d’amazonie

Dans l’intestin des habitants d’un village des montagnes vénézuéliennes, des chercheurs ont retrouvé des microbes dotés de résistance aux antibiotiques. Y compris aux molécules synthétiques utilisées comme médicaments en médecine occidentale.
Il est extrèmement rare, à notre époque, de trouver des êtres humains qui n’ont pas été influencés par la médecine occidentale. Ainsi, lorsqu’un petit village d’indigènes Yanomami a été découvert en 2008 par un survol en hélicoptère des montagnes du sud du Vénézuela, les chercheurs se sont bousculés pour pouvoir étudier leur état de santé « naturelle ».
Les habitants de ce petit village reculé, caché dans la jungle épaisse (dont le nom et l’emplacement on été tenus secrets) n’ont jamais consommé aucun médicament de synthèse, donc aucun antibiotique tueur de microbes. Pour les microbiologistes, ils représentent ainsi les sujets idéaux pour étudier le microbiote, c’est à dire l’ensemble de bactéries peuplant l’organisme humain (dans l’intestin, mais aussi sur la peau, dans la cavité buccale, etc.), qui participent à la fois à la digestion et à la défense contre les pathogènes.
Le microbiote recèle peut-être la clé pour soigner les pathologies chroniques
S’il intéresse les scientifiques, c’est que de plus en plus de recherches mettent en lumière son rôle clé dans une panoplie de maladies chroniques et métaboliques, diabète et obésité en tête (mais aussi divers troubles intestinaux comme la maladie de Crohn). En 2012, une équipe chinoise avait pour la première fois prouvé que la présence ou l’absence, dans le microbiote intestinal, de certaines espèces de bactéries, était associée au diabète de type 2.
En effet, notre microbiote se retrouve perturbé par la manière dons nous nous alimentons, nous lavons et nous soignons dans les sociétés au mode de vie occidental. En particulier, l’usage des médicaments antibiotiques, en tuant les bactéries responsables d’infections, élimine également les « bonnes » bactéries et déséquilibre la composition du microbiote.
60 gènes conférant une résistance aux antibiotiques recensés chez ces indigènes
Surtout, l’usage des antibiotiques, consommés en grande quantité depuis leur arrivée en masse sur le marché au cours du XXe siècle (au départ ils étaient prescrits sans ordonnance !) a ouvert la porte au développement de résistances chez les bactéries. Ce qui suscite beaucoup d’inquiétudes actuellement, face au constat que les souches bactériennes résistantes se multiplient, tandis que l’on manque de nouvelles molécules d’antibiotiques pour les combattre.
Or, en prélevant des échantillons dans les fèces et la bouche de 11 personnes parmi ces Yanomamis, l’équipe du microbiologiste Gautam Dantas de l’université Washington à St Louis (Missouri) a trouvé presque 60 gènes uniques destinés à défendre les bactéries contre 8 molécules antibiotiques en tout… Les résultats sont publiés dans la revue Science Advances.
Plus remarquable encore : certains de ces gènes leur confèrent même une résistance contre les antibiotiques les plus récents mis au point par l’industrie pharmaceutique : en particulier le gène codant l’enzyme cblA β-lactamase permet de résister à 5 antibiotiques de dernière génération, et le gène codant pour des protéines qui se lient à la pénicilline, qui résiste à la ceftazidime, un antibiotique de la classe des céphalosporines.
Les bactéries développeraient des armes contre les antibiotiques avant même d’y être exposées
Que signifie cette découverte ? Les auteurs s’inquiètent : elle montre que les bactéries s’arment naturellement contre des substances toxiques pour elles, même sans jamais être venues en contact avec celles-ci, en développant des outils de défense qui pourraient leur servir à l’avenir, en cas de rencontre. Les mécanismes de la résistance aux antibiotiques pourraient être encore plus affûtés qu’on ne le pensait, et ainsi la lutte contre ceux-ci plus difficile que prévu.
Par ailleurs, l’équipe de Maria Dominguez-Bello (Ecole de médecine de l’université de New York) a étudié la richesse du microbiote des Yanomamis. Elle a analysé des échantillons de fèces, de peau et de muqueuse buccale de 34 personnes parmi les 54 habitants du village isolé. Résultat : elle a découvert une richesse en espèces bactériennes jamais constatée ailleurs, en particulier dans l’intestin.
Un microbiote plus riche
Leur microbiote intestinal a une composition semblable, d’après les comparaisons effectuées, à celle d’une population d’Amérindiens ruraux de Colombie (les Guahibo) et une autre d’éleveurs du Malawi (Afrique), mais elle est beaucoup plus riche. En revanche, elle se distingue nettement de celui des d’Américains industrialisés par la présence de grandes quantités de Prevotella,Helicobacter, Oxalobacter et Spirochaeta, très réduites voire totalement absentes chez les humains industrialisés.
Si l’on ne connaît pas encore les bénéfices associés à ce mix particulièrement riche et divers d’espèces bactériennes chez les Yanomami, le personnel médical qui les a examinés a constaté qu’ils étaient tous en bonne santé : aucun cas de diabète, d’hypertension, de maladie cardiaque ou autoimmune. Seuls venaient les embarrasser des parasites et des petites infections respiratoires chez les enfants… à qui des médicaments ont donc été administrés.
Fiorenza Gracci – Science & Vie